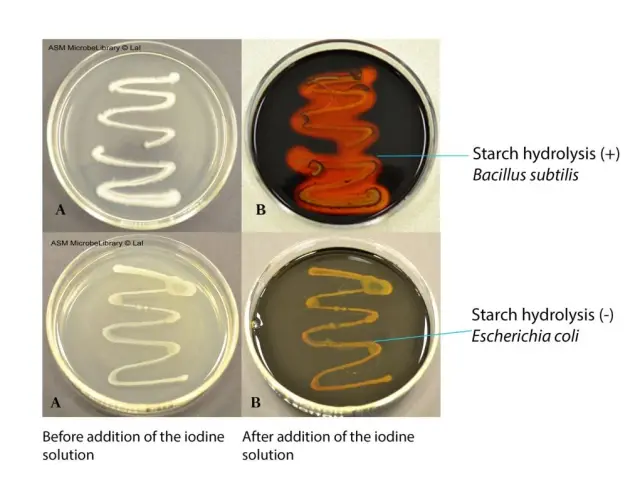
Starch Hydrolysis Test - Starch hydrolysis test (Image source: ASM)

Starch hydrolysis test is used to determine if the organism is capable of breaking down starch into maltose through the activity of the extra-cellular α-amylase enzyme. Starch, the most important source of carbohydrates for humans, is a polysaccharide mixture of two polymers, amylose, and amylopectin, the latter being predominant.
Amylose is a linear polysaccharide of several thousand α-D-glucose linked by 1,4-α-glycosidic bonds. Amylopectin is a branched-chain polysaccharide composed of glucose units linked primarily by α-1,4-glycosidic bonds but with occasional α-1,6-glycosidic bonds, which are responsible for the branching. Â

Principle
Starch molecules are too large to enter the bacterial cell, so only bacteria that secrete exoenzymes (α -amylase and oligo-1,6-glucosidase) are able to hydrolyze starch into subunits (dextrin, maltose, or glucose).  These molecules are readily transported into the bacterial cell to be used in metabolism.
In starch hydrolysis test (also known as amylase test), we use starch agar, which is a differential nutritive medium. The test organisms are inoculated onto a starch plate and incubated at 30°C until growth is seen (i.e. up to 48 hours).  The Petri plate is then flooded with an iodine solution.
If there is no enzyme present, and therefore no hydrolysis, the amylose, and iodine react together to form a blue color. Depending on the concentration of the iodine used,iodine turns blue, purple, or black in the presence of starch.
When bacteria capable of producing α-amylase and oligo-1,6-glucosidase are grown on starch agar, they secrete enzymes into the surrounding areas and hydrolyze the starch. As no amylose is present in the medium surrounding the bacterial colony, clearing around the bacterial growth is seen (there is no color development).
Materials
- Heart infusion agar with 2% starch or Mueller Hinton agar (MHA) (MHA contains amylose and thus can be used to test for starch hydrolysis, avoiding purchasing additional media.)
- Gram’s iodine
- Sterile sticks or inoculating loops
- Incubator
Quality Control
Inspect starch agar for freezing, contamination, cracks, and dehydration prior to storage and before use. Perform QC on each new lot of starch agar prior to using them. Test the performance of the agar using the following test organisms.
- S. bovis ATCC 33317—clear halo around colony with the addition of iodine (starch positive)
- Enterococcus faecalis ATCC 25922—blue color with the addition of iodine (starch negative)
Uses
****Starch hydrolysis test is used
- To differentiate members of various genera including Bacillus, Clostridium, Corynebacterium, Fusobacterium, Enterococcus, Pseudomonas, and Streptococcus. These genera have both amylase-positive and amylase-negative species.
- To separate Streptococcus bovis (positive) from other viridans group streptococci that are bile-esculin positive, 6.5% NaCl negative, and pyrrolidonyl-β-naphthylamide (PYR) negative.
Test Procedure
- Pick a few colonies of the test organism using a sterile swab or loop.
- Streak a starch plate in the form of a line across the width of the plate. Several cultures can be tested on a single agar plate, each represented by a line or the plate may be divided into four quadrants for this purpose.
- Incubate plate at 37 °C for 48 hours.
- Add 2-3 drops of 10% iodine solution directly onto the edge of colonies. Wait 10-15 minutes and record the results. Read plates immediately after the addition of iodine, as the blue color fades.
Interpretation
- Positive test (“+”): Characteristic purple-black color will appear in the medium. However, a clear halo will appear around the colonies of amylase-positive species. Catalase-negative, PYR-negative, Gram-positive cocci that are bile-esculin positive, do not grow on 6.5% salt, and hydrolyze starch are S. bovis.
- Negative test (“-“): Characteristic purple-black color will appear in the medium, right up to the edge of isolated colonies of amylase negative species.
| Starch hydrolysis (+ve) | Starch hydrolysis (-ve) |
|---|---|
| Bacillus subtilis | Streptococcus agalactiae |
| Bacillus cereus | Staphylococcus epidermidis |
| Bacillus megaterium | Escherichia coli |
Starch hydrolysis test results of selected organisms
Limitations
- Avoid using a glucose starch medium, since the metabolism of glucose may interfere with the assay.
- Once the iodine is added, the organisms are nonviable.
- A red-violet color is due to partial hydrolysis, and the test should be repeated after further incubation.
References and further reading
- Archana Lal, Naowarat Cheeptham. 2012. Starch agar protocol.
- Madigan MT, Martinko JM, Stahl DA, Clark DP. 2012. Brock biology of microorganisms, 13th ed. Benjamin Cummings, San Francisco, CA.
- Clinical Microbiology Procedures Handbook, Fourth Edition. (2016). In Clinical Microbiology Procedures Handbook, Fourth Edition. American Society of Microbiology. https://doi.org/10.1128/9781555818814